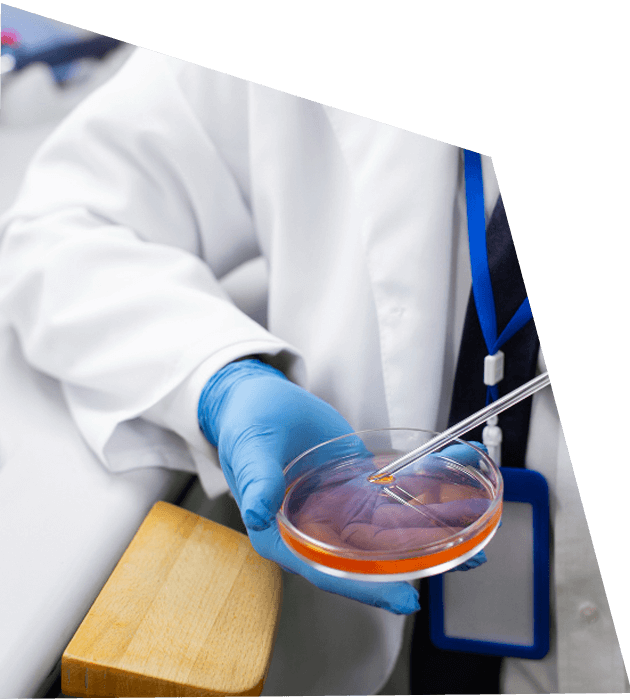

A personalized treatment that allows both partners in an LGBTQ+ relationship to take part biologically in conception and pregnancy.

Disclaimer: Clinic success rates can vary due to individual medical conditions, treatment plans, and patient profiles.

Partner A undergoes a personalized IVF protocol, including injectable fertility medications to stimulate multiple eggs and optimize embryo creation.

Eggs are carefully retrieved from Partner A’s ovaries and fertilized with donor sperm in our IVF lab to create viable embryos.

Our embryologists monitor and nurture embryos in the lab until they are ready for transfer or freezing, ensuring the best chance for a healthy pregnancy.

The embryos are transferred to Partner B’s uterus, either as a fresh transfer or following a preparation cycle, depending on what’s best for the couple.

Approximately nine days after transfer, Partner B returns to the clinic for blood tests to confirm pregnancy and ensure the early stages of development are progressing safely.

RIVF is ideal for same-sex female couples or cis female/trans male couples who:
Success depends on factors like the age of the egg-providing partner and any underlying fertility issues. Typically, younger egg-providing partners increase the chance of success.
Our New Patient Liaisons will connect with you within 48 hours to plan your first consultation.
We assess both partners to identify any fertility challenges and provide detailed insights.
Based on your evaluation, our care team collaborates with you to develop a plan tailored to achieve your family-building goals.
Patient stories can be inserted here, highlighting successful RIVF journeys.
“Choosing Reciprocal IVF with ConceptionIVF was the best decision we ever made. Taylor provided the eggs, and Mia carried our baby. The entire team guided us through every step with care and expertise. Holding our healthy baby for the first time felt like a dream come true!”
– Taylor & Mia, New York, NY
“We wanted both of us to play a biological role in our family. ConceptionIVF made it possible! From the first consultation to the embryo transfer, the doctors and staff were incredibly supportive and knowledgeable. Our journey was smooth, and our little one is perfect!”
– Jordan & Casey, Los Angeles, CA
“Reciprocal IVF allowed us to share the joy of creating our baby together. Partner A’s eggs, Partner B carrying—ConceptionIVF handled everything with professionalism and warmth. We always felt informed, cared for, and confident. We couldn’t be happier with our RIVF experience!”
– Riley & Harper, Chicago, IL
Learn everything you and your partner need to discuss before beginning RIVF, from treatment steps to emotional readiness.

Reciprocal IVF allows both partners in a same-sex female or cis female/trans male couple to play a biological role. Partner A provides the eggs, which are fertilized with donor sperm to create embryos. Partner B then carries the embryo in her uterus, resulting in shared parenthood.
RIVF is ideal for couples where both partners want to be biologically involved in the pregnancy and are medically suitable for IVF and pregnancy. Your fertility team will assess both partners to confirm candidacy.
Typically, one partner provides the eggs (Partner A), and the other carries the pregnancy (Partner B). Which partner plays each role is decided based on personal preference, fertility factors, and medical evaluation.
The full RIVF process usually takes 6–8 weeks, including ovarian stimulation, egg retrieval, embryo development, and embryo transfer. Exact timing may vary depending on your cycle and clinic scheduling.
Success depends on the age of the egg-providing partner and any underlying fertility issues. Generally, younger egg donors have higher success rates, similar to traditional IVF. ConceptionIVF consistently reports strong outcomes thanks to our experienced team and advanced lab technology.
Yes. Many couples choose to use the same donor for multiple cycles to maintain genetic consistency across siblings. Your fertility team can guide you through planning future pregnancies.
RIVF costs vary based on treatment complexity, medications, and lab procedures. Some insurance plans offer partial coverage for IVF services, but coverage for reciprocal IVF specifically is limited. ConceptionIVF provides detailed cost estimates and financing options during your consultation.
We combine compassionate, LGBTQ+ affirming care with board-certified reproductive endocrinologists, a state-of-the-art IVF lab, and personalized treatment plans. Our team is dedicated to helping both partners play a role in creating their family, with guidance every step of the way.
Our board-certified reproductive endocrinologists are ready to help you create the family you dream of.


You’ll find everything you need here: a full spectrum of services, our award-winning laboratory, and heartfelt support for your mind and body.
All Rights Reserved to ConceptionIVF